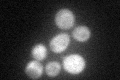
YKL142W
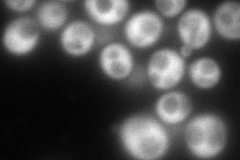
YKL142W
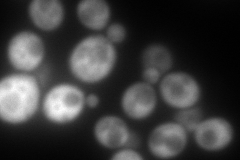
YKL142W
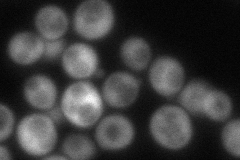
YKL142W
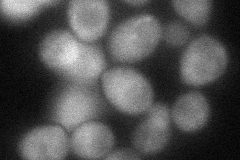
YKL142W
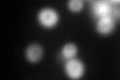
YKL142W
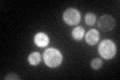
YKL142W

View description
Protein of unknown function; undergoes sumoylation; transcription induced under cell wall stress; protein levels are reduced under anaerobic conditions; originally thought to be a mitochondrial ribosomal protein based on sequence analysis
Localization:
Intensity:
Fold change:
Significance:
-
C’ GFP library in SD
cytosol59.35 -
N' NOP1pr-GFP in SD
cytosol237.942 -
N' TEF2pr-mCherry in SD
cytosol342.313 -
N' NATIVEpr-GFP in SD
cytosol105.421 -
N' TEF2pr-VC and Cyto-VN in SD
cytosol61.426 -
C’ GFP library in SD+DTT
cytosol117.411.97Yes -
C’ GFP library in SD+H2O2

cytosol42.40.71No -
C’ GFP library in Starvation Media
cytosol119.632.01Yes -
C’ GFP library on the background of Pup2-DaMP

cytosol -
C’ GFP library on the background of CCT mutant

cytosol55.0480.927445No
